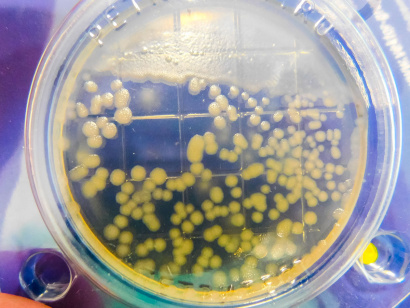
Экспресс-тест ОМЧ/КМАФАнМ (петритест)  Аналог 3M Petrifilm (AC) 3М Petrifilm (RAC)

О товаре
Готовый экспресс-тест для микробиологического анализа сырья, полуфабрикатов, готовых продуктов питания, окружающей среды и пр. Тщательный биоконтроль на предприятиях пищевой отрасли и в быту для определения микробиологической безопасности пищи, воды, жилого или рабочего пространства.
При помощи тест подложек Петритест можно делать смывы.
- Соответствуют требованиям действующего санитарного законодательства РФ
- Срок годности – два года!
- Не требует специальный условий хранения.
- Возможность визуализировать колонии по цвету.
- Удобство подсчета колоний.
- Соответствует классическим методам исследований.
- Результаты через 24 часа.
Стоимость одного анализа от 80 рублей.
Категории
Экспресс-тест ОМЧ/КМАФАнМ
сухой
Аналог 3M Petrifilm (AC) 3М Petrifilm (RAC)
Результаты через 24 часа.
Последнее обновление 01.02.2026 г., количество просмотров: 338
Сообщить об ошибке

С помощью теста можно более гибко организовывать работу лаборатории – проводить анализы на удаленных объектах (магазинах, складах, в полевых условиях). Как результат – увеличивается скорость получения результатов. Нам подошел идеально. Рекомендую!